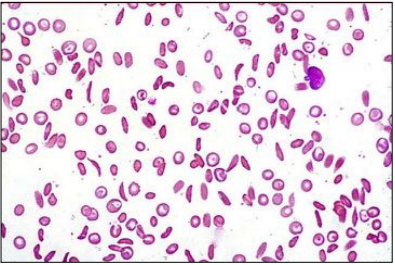
Enunciado 4577374-1

Foram encontradas 80 questões.
A tipagem ABO e Rh de um doador de sangue de 1ª vez mostrou os seguintes resultados:

O laboratório realizou uma técnica para excluir D fraco e D parcial, em gel, e o resultado final estabeleceu que o paciente era D fraco.
Com isso, a bolsa de concentrado de hemácias preparada a partir dessa doação deve ser rotulada como:
Provas
Questão presente nas seguintes provas
Um jovem de 18 anos de idade procura médico com quadro de
adenomegalia cervical. Ao exame físico, há gânglios indolores e
aumentados de volume em cadeia cervical, bilateralmente.
Tomografia computadorizada de tórax é normal, e a ressonância
magnética de abdômen mostra esplenomegalia moderada, sem
hepatomegalia e sem adenomegalias abdominais ou
retroperitoniais. A biópsia de linfonodo e a imuno-histoquímica
são compatíveis com doença de Hodgkin.
Diante desse quadro, o estadiamento da doença é:
Diante desse quadro, o estadiamento da doença é:
Provas
Questão presente nas seguintes provas
Um paciente do sexo masculino, 32 anos de idade, desenvolve
um quadro agudo de isquemia cerebral e é internado. No
hemograma, as séries branca e vermelha estão normais, mas há
plaquetopenia (10.000 plaquetas/µL). No esfregaço do sangue
periférico, há esquizócitos. Os exames bioquímicos mostram
marcada elevação de LDH, marcadores de função renal e hepática
normais e diminuição dos níveis de ADAMTS-13.
O diagnóstico mais provável é:
O diagnóstico mais provável é:
Provas
Questão presente nas seguintes provas
Uma paciente de 18 anos de idade tem o diagnóstico de anemia
aplástica confirmado pela biópsia de medula óssea, que mostrou
uma celularidade inferior a 15%, com células hematológicas
residuais inferiores a 20%. Seu hemograma de internação mostra
hemoglobina de 5 g/dL, contagem de granulócitos de 180/µL,
contagem de plaquetas de 8.000/µL e reticulócitos inferiores a
20.000/µL.
O tratamento de primeira linha dessa paciente deve ser feito com:
O tratamento de primeira linha dessa paciente deve ser feito com:
Provas
Questão presente nas seguintes provas
Um paciente portador de leucemia mieloide aguda foi submetido
a um transplante de medula óssea alogênico. Três semanas após,
quando já havia ocorrido a “pega” do transplante, começa a
apresentar rash cutâneo não pruriginoso generalizado e diarreia
sanguinolenta. As provas de função hepática mostravam
aumento significativo de ALT, AST e bilirrubinas. No hemograma –
que três dias antes estava próximo da normalidade, com anemia
leve (10 g/dL de hemoglobina, trombocitopenia moderada
(80.000 plaquetas/µL) e neutrófilos de 1.200 /µL – houve piora da
anemia (hemogoblina: 7 g/dL) e da trombocitopenia
(30.000 plaquetas/µL).
Diante desse quadro, o diagnóstico mais provável é:
Diante desse quadro, o diagnóstico mais provável é:
Provas
Questão presente nas seguintes provas
A situação clínica na qual o uso da solução de albumina humana a
20% está indicado é:
Provas
Questão presente nas seguintes provas
Um paciente de 60 anos de idade, 50 kg, portador de mieloma
múltiplo, será submetido a um transplante autólogo de medula
óssea. O volume total de células-tronco coletadas por aférese foi
de 250 mL, e a contagem de células CD34+ no produto foi de
600 células/µL.
Com base nesses resultados, é correto afirmar, acerca do número de células-tronco CD34+ colhidas, que:
Com base nesses resultados, é correto afirmar, acerca do número de células-tronco CD34+ colhidas, que:
Provas
Questão presente nas seguintes provas
Uma criança de 5 anos de idade é encaminhada para o
hematologista com história de anemia crônica, infecções de
repetição e crises álgicas esporádicas. O hematologista faz um
esfregaço do sangue periférico, cuja imagem pode ser vista
abaixo.

Com base na história e na imagem, o diagnóstico provável é:
Com base na história e na imagem, o diagnóstico provável é:
Provas
Questão presente nas seguintes provas
Em relação à data para a qual uma transfusão está programada
para um paciente que nunca foi previamente transfundido, a
coleta de amostra do paciente para a pesquisa pré-transfusional
de anticorpos irregulares (P.A.I.) precisa ser feita até:
Provas
Questão presente nas seguintes provas
Um paciente de 58 anos, portador de mieloma múltiplo, é
encaminhado para se submeter a um segundo transplante de
medula óssea. 1 ano antes, havia sido submetido a um primeiro
transplante de medula autólogo. Naquela ocasião, a coleta de
células-tronco CD34+ do sangue periférico, após uso do agente
mobilizador habitual, resultou pouco frutífera, tendo-se atingido
o número mínimo de células para o transplante após quatro
coletas subsequentes, ao longo de 3 dias.
Para o novo transplante, a recomendação para aumentar a probabilidade de êxito da mobilização pré-coleta é:
Para o novo transplante, a recomendação para aumentar a probabilidade de êxito da mobilização pré-coleta é:
Provas
Questão presente nas seguintes provas
Cadernos
Caderno Container